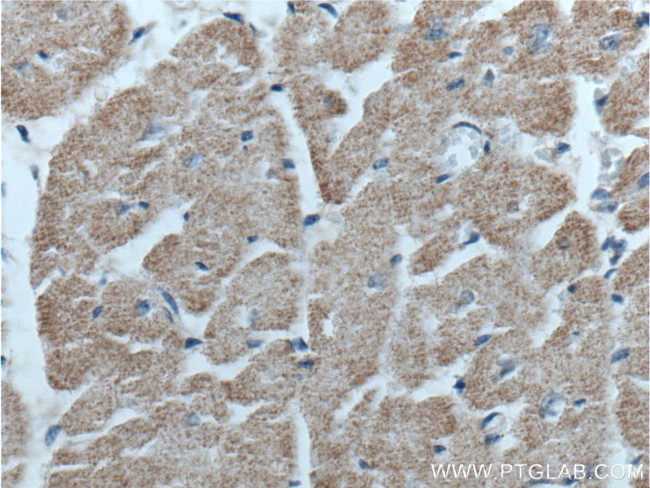
GFRA3 Antibody in Immunohistochemistry (Paraffin) (IHC (P))

Search
Proteintech
GFRA3 Polyclonal Antibody
{{$productOrderCtrl.translations['antibody.pdp.commerceCard.promotion.promotions']}}
{{$productOrderCtrl.translations['antibody.pdp.commerceCard.promotion.viewpromo']}}
{{$productOrderCtrl.translations['antibody.pdp.commerceCard.promotion.promocode']}}: {{promo.promoCode}} {{promo.promoTitle}} {{promo.promoDescription}}. {{$productOrderCtrl.translations['antibody.pdp.commerceCard.promotion.learnmore']}}
产品信息
25379-1-AP
种属反应
宿主/亚型
分类
类型
抗原
偶联物
形式
浓度
规格
纯化类型
保存液
内含物
保存条件
运输条件
产品详细信息
Immunogen sequence: SRLMNSCLQ ARRKCQADPT CSAAYHHLDS CTSSISTPLP SEEPSVPADC LEAAQQLRNS SLIGCMCHRR MKNQVACLDI YWTVHRARSL GNYELDVSPY EDTVTSKPWK MNLSKLNMLK PDSDLCLKFA MLCTLNDKCD RLRKAYGEAC SGPHCQRHVC LRQLLTFFEK AAEPHAQGLL LCPCAPNDRG CGERRRNTIA PNCALPPVAP NCLELRRLCF SDPLCRSRLV DFQTHCHPMD ILGTCATEQS RCLRAYLGLI GTAMTPNFVS NVNTSVALSC TCRGSGNLQE ECEMLEGFFS HNPCLTEAIA AKMRFHSQLF SQDWPHPTFA VMAHQNENPA VRP (38-379 aa encoded by BC037951)
靶标信息
GFRa-3 binds persephin, thus, persephin, GFRa-3, and Ret PTK form a complex to transduce persephin signal and to mediate persephin function.
仅用于科研。不用于诊断过程。未经明确授权不得转售。
篇参考文献 (0)
生物信息学
蛋白别名: GDNF family receptor alpha-3; GDNF receptor alpha-3; GDNF receptor alpha-3 variant; GDNFR-alpha-3; GFR alpha-3; GFR-alpha-3; GFRalpha3; glial cell line-derived neurotrophic factor receptor alpha-3; GPI-linked receptor; unnamed protein product
基因别名: GDNFR3; GFRA3; GFRalpha3; UNQ339/PRO538/PRO3664; Y15110
UniProt ID: (Human) O60609, (Mouse) O35118
Entrez Gene ID: (Human) 2676, (Mouse) 14587